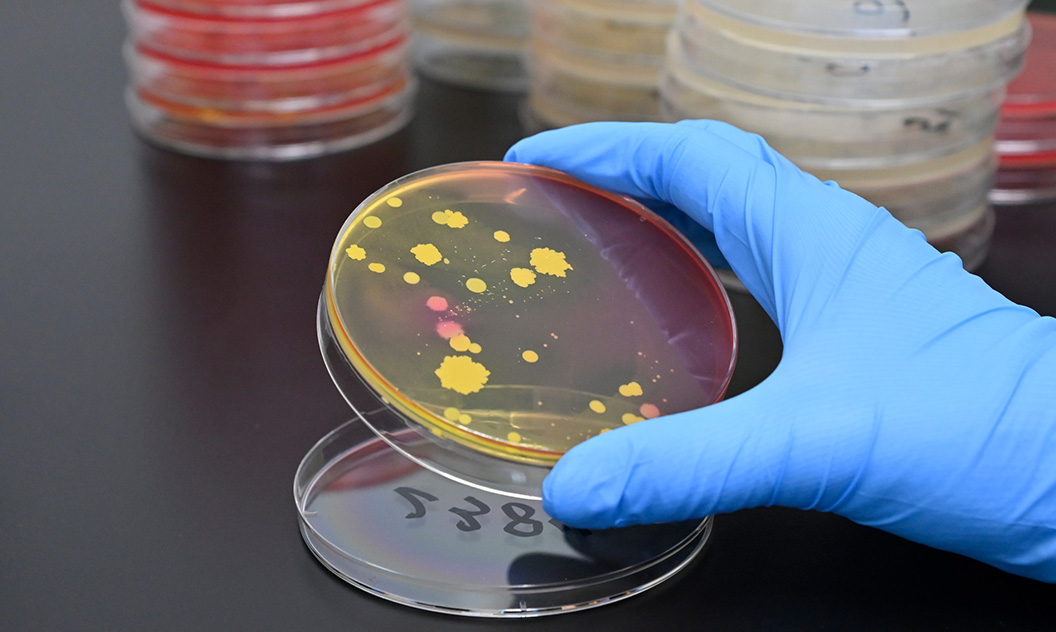
食品検査の様子

センター概要
1973年度の財団法人設立から現在に至るまでの、公衛検の業務を中心としての歴史です。
事業紹介
各画像をクリックすると、それぞれの事業の紹介ページへ移動します。
医薬品試験

医薬品、医薬品原料、医薬部外品、医薬品容器等は安全性が確保されていなければなりません。
公衛検では、医薬品等の品質確保を図るため、日本薬局方に基づく理化学検査や微生物検査など様々な検査を行い、正確なデータと安心をお届けします。
食品検査
近年、食品の安全・安心についての関心は非常に高くなっています。
公衛検では、栄養成分検査、消費期限・賞味期限設定のための食品検査、衛生管理に伴う検査としてのふきとり検査・微生物検査を行い、正確なデータと安心をお届けします。
水質検査

水は私たちの生活に欠かせないものです。
公衛検では、水を安全に安心して使用するため、環境を保護するために、 様々な法律で規制されている検査を行い、正確なデータと安心をお届けします。
環境測定・環境調査

人と自然が調和する快適な生活環境づくりに貢献します。
公衛検では、長年にわたり積み重ねてきた実績と専門技術を基に、大気、排ガス、悪臭、土壌等の分析から、音圧レベル、振動加速度レベル、作業環境測定と幅広い分野にわたり、分析・調査・測定サービスを行い、正確なデータと安心をお届けします。
臨床検査(腸内細菌検査)

私たちは、衛生管理に努め、また、新しい命を守っています。
公衛検では、食中毒事故の発生を未然に防ぐための手段の一つとして、腸内細菌検査を承っております。
また、先天性疾患の早期発見、治療、予防を目的とした新生児マス・スクリーニング検査を行い、正確なデータと安心をお届けします。
環境計画・環境アセスメント・廃棄物コンサルティング

循環型社会の形成に向けた取り組みを推進するため、環境計画の策定、環境アセスメントの実施及び廃棄物処理・処分施設の建設・管理を支援しています。
浸出性能試験

公衛検では、“水道用器具”、“水道用薬品”、“水道用資機材”に関する浸出性能試験等の検査を実施しています。
製品の品質管理、納品前の品質確認に検査を行ってはいかがでしょうか。
特殊分析

私たちの身のまわりには、ごく微量レベルでも健康影響や生体影響が懸念される物質が多くあります。
公衛検では、高精度な機器と高度な技術力を活用して、環境中のPCBやアスベスト、ダイオキシン類による汚染等のさまざまな環境問題に対し、検査・分析を行い、正確なデータと安心をお届けします。

